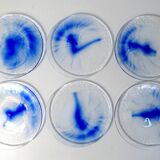
6 assiettes bleu cobalt Bormioli Rocco

Indisponible
Page 1 of 7
6 assiettes bleu cobalt Bormioli Rocco
Ce produit a trouvé preneur, mais d'autres pièces uniques vous attendent. 👇
Parcourir les pièces similaires- Dimensions :
- H1 x L20 x P20
- Couleur :
- bleu
- Matériaux :
- verre et cristal
- Style :
- vintage
6 petites assiettes pour hors d’œuvre, fromage, ou dessert. En verre transparent, bleu cobalt, par Bormioli Rocco. Diamètre: 20 cm. Hauteur: 1, 5 cm. Elle sont en bon état avec des traces d'usage: usure du verre au centre des assiettes.